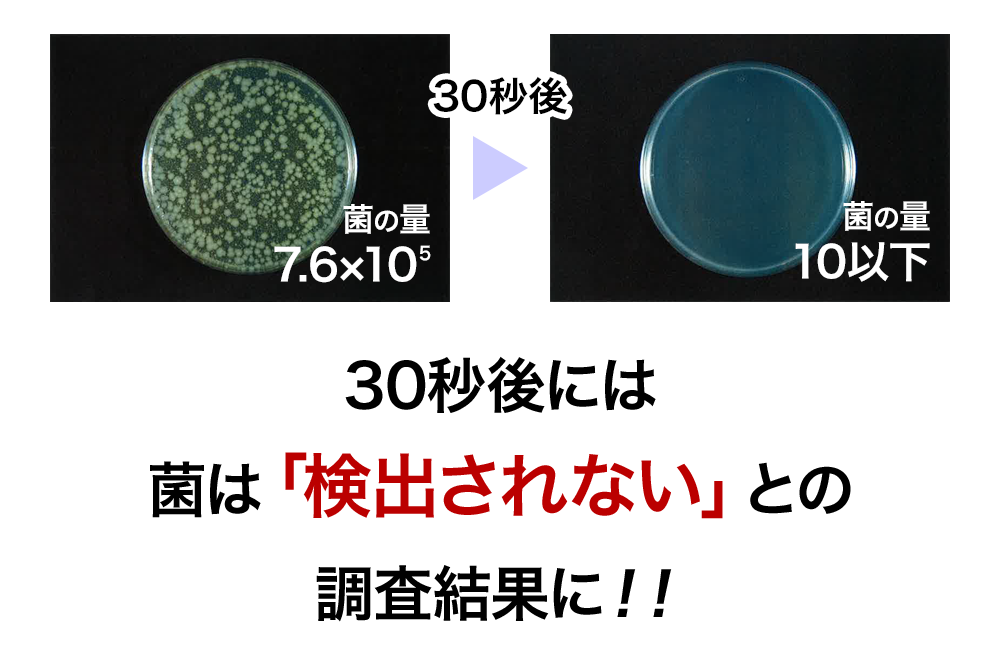
30秒後には「菌は検出されない」との調査結果に！！

身体にも安全・安心な
除菌剤を使いたい…
除菌剤を一括購入しても
期限内に使いきれないかも…
除菌剤を一括購入したいけど
置く場所がない…

除菌のミカタの効果がどのように表れるのか、市販されているアルコールや次亜塩素酸水をルミテスターによる比較実験を行いました!

雑菌によるニオイを香料で紛らわすのではなく、ニオイのもと「菌」に働きかけることで、あのイヤなニオイを原因から解決。
試験結果でも実証された高い消臭率で、約15分後には50%以上の消臭効果が期待できます!

| アンモニア濃度 | 100ppm(実験チャンバー20L) |
|---|---|
| 除菌のミカタ水溶液12ppm(1Lに1包分) | 15mL |

| トリメチルアミン濃度 | 100ppm(実験チャンバー20L) |
|---|---|
| 除菌のミカタ水溶液12ppm(1Lに1包分) | 15mL |
除菌のミカタ100ppmという高い濃度の除菌水に各種テストピースを1枚ずつ入れ、30日後の腐敗状況を観察したました。
その結果、いずれのテストピースも腐食することがありませんでした。

※腐食測定機関:Ecoworld社研究所



これまでの次亜塩素酸では効果がなかった大腸菌の殺菌もオゾンを含む「除菌のミカタ」なら効果があります。食中毒の原因になる黄色ブドウ球菌、カンジタ菌、ネコカリシウィルス、セレウス菌に従来の次亜塩素酸よりも少量で大きな効果があることが実験結果からわかっています。





当社は福祉施設を運営しており、用途に合わせて希釈して使用しています。
今まで20Lの水溶液を仕入れていた為、収納スペースに苦戦していました。除菌のミカタは粉末状の為、場所も取らず助かっています。
また送料が安いのも選んだポイントです!
埼玉県在中
障害者施設運営 藤本理事長

除菌のミカタは手のひらサイズで場所も取らないので保管しやすいです。
塩素の匂いも気にならないですし、中性に近い水溶液で安全なので安心して気にせずに様々な場所で使用しています。
佐賀県在中
保育士 永利先生
貴社名
ご担当者名必須
電話番号必須
メールアドレス
お問い合わせ種別必須
お問い合わせ内容